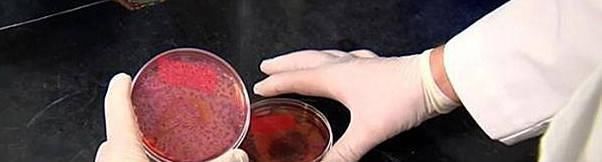
大厨|大厨教你粉条不粘锅又好吃的做法,一学就会,比饭店做的还好吃

大厨|大厨教你粉条不粘锅又好吃的做法,一学就会,比饭店做的还好吃

文章图片
【粉丝炒黄豆芽】
材料:粉条1把,黄豆芽,盐,青红椒少许,香油,玉米油,干辣椒,胡椒粉,无添加酱油,大蒜
【做法】1、粉条温水下锅,水开后煮1分钟,七成熟时用漏勺捞出,沥干水分,用筷子挑一挑,使粉条快速降温,然后装进一大盆中,加入适量玉米油拌一拌,目的是防止粘连,然后加入一点胡椒粉、香油适量、无添加酱油适量,拌匀备用
文章图片
2、就煮粉条水烧开,放入黄豆芽煮1分钟,去除豆腥味,煮7成熟捞出控水。
3、青红椒切丝,大蒜拍碎,干辣椒切段。
4、热锅冷油,端起锅滑一下油,放入大蒜、干辣椒大火爆香,然后放入粉条翻炒,炒香炒透粉条放入黄豆芽、青红椒丝一同翻炒。
5、炒1分钟炒熟豆芽,出锅。粉条软糯,黄豆芽清脆,越吃越香!
【 大厨|大厨教你粉条不粘锅又好吃的做法,一学就会,比饭店做的还好吃】

文章图片
- 猪肉|东北不但有酸菜猪肉炖粉条,还有酸鲜够味的它,蒸一锅热乎又好吃
- 煎鱼|煎鱼时,直接下锅煎是大错!大厨教你一招,不粘锅不掉皮
- 方法|切开的南瓜别直接放冰箱,教你一个方法,保存一个月都不坏!
- 酱料|想吃铁板豆腐,在家教你做,搭配2种酱料,酸辣味美,家人特爱吃
- 蛋糕|教你做个不一样的蛋糕,不用油不用奶,第二天依旧美味还能当早餐
- 肉馅|教你做好吃的肉丸子,滑嫩Q弹味道鲜美,冬天吃既美味又解馋
- 版水|教你家常版水煮肉片,肉片滑嫩无比,鲜香入味,几分钟就能搞定
- 豆腐|精选美食推荐:白菜豆腐炖粉条,肉末豆腐,家常红烧肉的做法
- 做出|家常麻婆豆腐,按这个步骤来,在家也能做出大厨味,香嫩又可口
- 简单|金针菇别再涮火锅,教你个新吃法,简单一做外酥里嫩,比肉还好吃
